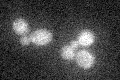
YIR029W
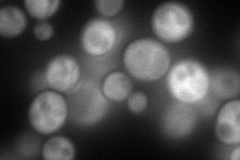
YIR029W
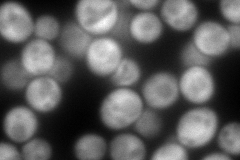
YIR029W
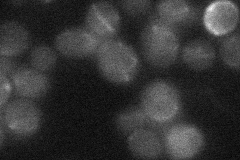
YIR029W
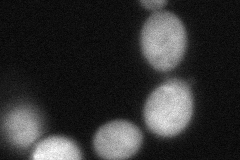
YIR029W

View description
Allantoicase, converts allantoate to urea and ureidoglycolate in the second step of allantoin degradation; expression sensitive to nitrogen catabolite repression and induced by allophanate, an intermediate in allantoin degradation
Localization:
Intensity:
Fold change:
Significance:
-
C’ GFP library in SD
below threshold15.96 -
N' NOP1pr-GFP in SD
cytosol174.475 -
N' TEF2pr-mCherry in SD
cytosol295.545 -
N' NATIVEpr-GFP in SD
nucleus18.5069 -
N' TEF2pr-VC and Cyto-VN in SD
cytosol79.7361 -
C’ GFP library in SD+DTT

cytosol17.251.08No -
C’ GFP library in SD+H2O2

cytosol16.871.05No -
C’ GFP library in Starvation Media

cytosol14.670.91No -
C’ GFP library on the background of Pup2-DaMP

below threshold -
C’ GFP library on the background of CCT mutant

below threshold17.11861.07178No
